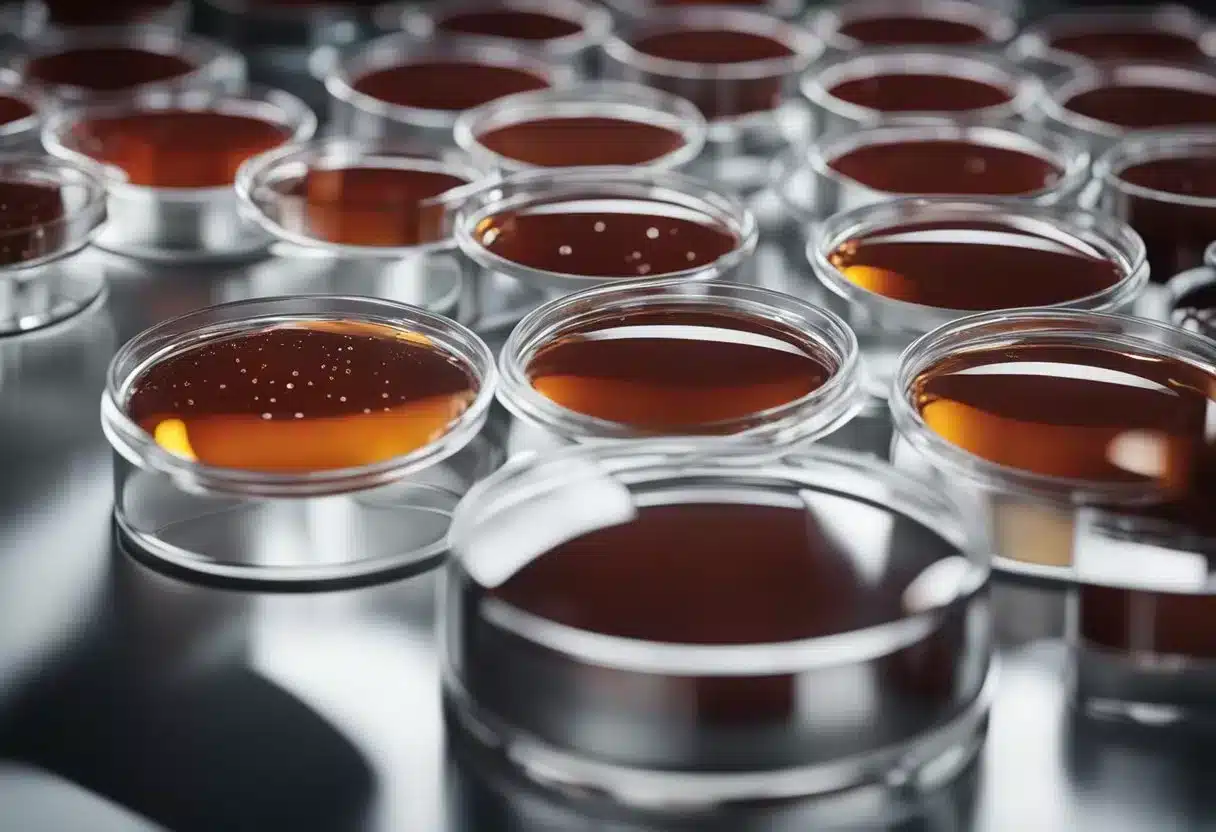
Blood mixes with stool in a clear container, highlighting the presence of blood in the sample. A diagnostic tool, such as a test strip or microscope, is nearby for further examination

Blood in stool can be alarming, but it’s important to stay calm and understand what it might mean. Many causes of bloody stools are not serious and can be treated easily. The color of the blood can provide clues about where the bleeding is coming from in your digestive system.
Rectal bleeding can range from mild to severe. Bright red blood often suggests bleeding in the lower part of the digestive tract, while darker blood may indicate bleeding higher up. Common causes include hemorrhoids, anal fissures, and inflammatory bowel diseases.
It’s crucial to pay attention to other symptoms that might occur with bloody stools. Abdominal pain, changes in bowel habits, or unexplained weight loss could point to more serious conditions. If you notice blood in your stool[1], it’s best to consult a doctor for proper evaluation and treatment.
Key Takeaways
- Blood in stool can range from mild to serious, with color indicating the potential source
- Common causes include hemorrhoids, anal fissures, and inflammatory bowel diseases
- Seek medical attention if blood in stool persists or is accompanied by other symptoms
Understanding Blood in Stool

Blood in stool can be a concerning symptom. It can appear in different ways and have various causes. Knowing what to look for helps people spot potential issues early.
Characteristics of Blood in Stool
Blood in stool can look different depending on where it comes from in the digestive system. Fresh, bright red blood often means the bleeding is in the lower part of the gut. This is called hematochezia.
Dark, tarry stools point to bleeding higher up in the digestive tract. Doctors call this melena. The blood turns dark as it moves through the gut.
Sometimes, blood isn’t visible to the eye. Special tests can find hidden blood in stool samples.
Common Terminology
Several terms describe blood in stool:
- Rectal bleeding: This means any blood coming from the rectum or anus.
- Hematochezia: Bright red blood in or on the stool.
- Melena: Dark, tarry stools due to digested blood.
- Occult blood: Blood in stool that can’t be seen without testing.
Doctors use these terms to help figure out where the bleeding might be coming from. Hemorrhoids often cause bright red blood on toilet paper or in the toilet bowl. Darker blood might mean the problem is higher up in the gut.
Potential Causes of Blood in Stool

Blood in stool can result from various conditions affecting different parts of the digestive system. These range from minor issues to more serious diseases that require prompt medical attention.
Hemorrhoids and Anal Fissures
Hemorrhoids are swollen veins in the lower rectum or anus. They often cause bright red blood on toilet paper or in the bowl. Straining during bowel movements can worsen hemorrhoids.
Anal fissures are small tears in the lining of the anus. They can cause pain and bleeding during bowel movements. Passing hard stools is a common cause of fissures.
Both conditions are usually not serious but can be uncomfortable. Simple treatments like creams, warm baths, and dietary changes often help.
Peptic Ulcers and GI Bleeding
Peptic ulcers are sores in the stomach or small intestine lining. They can cause bleeding in the upper GI tract. This blood may appear dark or tar-like in stools.
Other causes of upper GI bleeding include:
- Gastritis (stomach inflammation)
- Esophageal tears
- Stomach or esophageal varices
These conditions can lead to more severe blood loss. Symptoms may include weakness, dizziness, and shortness of breath.
Inflammatory Bowel Diseases
Inflammatory bowel diseases like Crohn’s disease and ulcerative colitis can cause blood in stool. These conditions involve chronic inflammation of the digestive tract.
Symptoms often include:
- Abdominal pain
- Diarrhea
- Weight loss
- Fatigue
The blood may be mixed with mucus in the stool. Treatment usually involves medications to reduce inflammation and manage symptoms.
Diverticular Disease and Polyps
Diverticular disease occurs when small pouches form in the colon wall. These pouches can bleed or become infected, leading to blood in stool.
Colon polyps are growths on the inner lining of the colon. While often harmless, some can bleed or develop into cancer over time.
Both conditions may not cause symptoms until bleeding occurs. Regular screenings can help detect and treat these issues early.
Colorectal Cancer and Tumors
Colorectal cancer[1] is a serious cause of blood in stool. It may start as polyps that grow and bleed. Other symptoms can include:
- Changes in bowel habits
- Unexplained weight loss
- Fatigue
Early detection through screening is key for successful treatment. Anyone with persistent blood in stool should see a doctor promptly.
Infections and Inflammatory Conditions
Various infections can cause bloody stools. These include:
- Bacterial infections (like E. coli)
- Parasitic infections
- Viral gastroenteritis
Inflammatory conditions like colitis can also lead to blood in stool. These often cause other symptoms like fever, abdominal pain, and diarrhea.
Proper diagnosis is important for effective treatment. This may involve stool tests or other diagnostic procedures.
Other Gastrointestinal Issues
Several other conditions can cause blood in stool:
- Angiodysplasia (abnormal blood vessels in the GI tract)
- Meckel’s diverticulum (a pouch in the small intestine)
- Radiation proctitis (damage from radiation therapy)
These conditions may require specialized treatments. A thorough medical evaluation can help identify the specific cause and guide appropriate management.
Symptoms Accompanying Blood in Stool

Blood in stool can come with other signs. These may point to the cause or how serious it is. Look out for pain, stomach issues, and changes in your body.
Pain and Discomfort
Abdominal pain often goes with blood in stool. It can range from mild to severe. The pain may be:
- Sharp or dull
- Constant or come and go
- In one spot or all over the belly
Chest pain can happen if there’s a lot of bleeding. Some people feel pain when they poop. This might mean they have hemorrhoids or anal fissures[2].
Digestive System Symptoms
The digestive system can act up when there’s blood in stool. Common issues are:
- Nausea and vomiting
- Changes in bowel habits
- Constipation or diarrhea
- Bloating or gas
Some may see black, tarry stools. This can mean bleeding higher up in the gut. Bright red blood often comes from the lower gut or anus[3].
Systemic Symptoms
Blood in stool can affect the whole body. People might feel:
- Weak or tired
- Dizzy or lightheaded
- Short of breath
These signs can mean a lot of blood loss. Anemia may develop if bleeding goes on for a while. Some might have fever or lose weight without trying.
If fainting or trouble breathing happen, it’s very serious. People should get help right away.
Diagnostic Procedures
Doctors use several methods to find the cause of blood in stool. These range from simple physical exams to more complex imaging studies. The right tests help pinpoint the problem and guide treatment.
Physical Examination and Lab Tests
A doctor starts with a rectal exam to check for visible issues. They insert a gloved finger into the rectum to feel for abnormal growths or tender areas.
Blood tests check for anemia or infections. Stool samples can reveal hidden blood not seen by the eye. This is called occult blood testing.
Doctors may also order other lab tests to check organ function and look for signs of disease.
Endoscopy and Colonoscopy
Endoscopy[4] lets doctors see inside the upper digestive tract. A thin tube with a camera goes down the throat to examine the esophagus, stomach, and small intestine.
Colonoscopy looks at the large intestine and rectum. A long, flexible tube with a camera enters through the anus. It can find polyps, tumors, or areas of inflammation.
Both procedures allow doctors to take tissue samples for testing. They can also treat some problems during the exam.
Imaging Studies
CT scans[4] create detailed images of the digestive system. They can show tumors, inflammation, or other issues causing bleeding.
X-rays with contrast dye highlight areas of the digestive tract. This helps find ulcers, blockages, or other problems.
Ultrasound uses sound waves to create images. It’s useful for checking organs like the liver and gallbladder.
These tests help when endoscopy can’t reach an area or more information is needed.
Treatment and Management

Treatment for blood in stool aims to address the underlying cause. The approach may involve medication, lifestyle changes, or surgery depending on the specific condition.
Medication and Therapeutics
Doctors often prescribe medications to treat the root cause of bloody stools. For hemorrhoids or anal fissures, topical creams or ointments can help reduce swelling and discomfort.
Anti-inflammatory drugs may be used for conditions like inflammatory bowel disease. These help decrease inflammation in the digestive tract.
For infections, antibiotics are commonly prescribed. In cases of severe bleeding, doctors might give blood thinners or clotting factors.
A gastroenterologist may recommend iron supplements if blood loss has led to anemia.
Diet and Lifestyle Changes
Making changes to diet and daily habits can often help manage bloody stools. Increasing fiber intake through fruits, vegetables, and whole grains can ease constipation and reduce strain during bowel movements.
Staying hydrated is key. Drinking plenty of water helps soften stools and prevent further irritation.
For some conditions, avoiding certain foods may help:
- Spicy foods
- Alcohol
- Caffeine
Regular exercise can improve overall digestive health. Stress reduction techniques like meditation may also be beneficial.
Avoiding straining during bowel movements[4] is important to prevent hemorrhoids and fissures.
Surgical Interventions
In some cases, surgery may be necessary to treat the cause of blood in stool. For severe hemorrhoids that don’t respond to other treatments, a hemorrhoidectomy might be performed.
For polyps or tumors, surgical removal is often required. This can be done through colonoscopy for smaller growths or open surgery for larger ones.
In cases of diverticulitis or inflammatory bowel disease, surgery to remove damaged portions of the colon may be needed.
For bleeding ulcers, endoscopic procedures can be used to stop the bleeding and repair the damaged area.
Preventing Blood in Stool
Blood in stool can often be prevented through simple lifestyle changes and regular medical care. Taking proactive steps can help maintain digestive health and catch potential issues early.
Dietary and Lifestyle Advice
A healthy diet plays a key role in preventing blood in stool. Eat plenty of fiber-rich foods like fruits, vegetables, and whole grains. These help prevent constipation, which can lead to straining and bleeding.
Stay hydrated by drinking enough water each day. This keeps stools soft and easy to pass. Limit alcohol and caffeine, as they can irritate the digestive tract.
Regular exercise improves digestion and bowel function. Aim for at least 30 minutes of moderate activity most days of the week.
Avoid straining during bowel movements. Don’t sit on the toilet for long periods. Use proper posture while on the toilet to reduce pressure on the anal area.
Maintain a healthy weight. Obesity can increase the risk of digestive issues that may cause bleeding.
Regular Health Screenings
Regular check-ups help catch potential problems early. Adults should discuss appropriate colorectal cancer screenings[1] with their doctor. These often start at age 45 for average-risk individuals.
Screenings may include:
- Colonoscopy
- Fecal occult blood test
- Sigmoidoscopy
- Stool DNA test
People with a family history of colorectal cancer or other risk factors may need to start screenings earlier or have them more frequently.
During check-ups, be open with your doctor about any digestive symptoms or changes in bowel habits.
Recognizing Early Symptoms
Being aware of early warning signs can help prevent serious issues. Pay attention to changes in bowel habits, such as:
- Persistent diarrhea or constipation
- Narrow stools
- Feeling like the bowel doesn’t empty completely
Watch for signs of bleeding[5] in the stool, toilet paper, or toilet bowl. This includes bright red blood, dark or tarry stools, or stools with a red tinge.
Other symptoms to note:
- Unexplained weight loss
- Abdominal pain or cramping
- Fatigue or weakness
If any of these symptoms occur, especially if they persist, contact a healthcare provider promptly for evaluation.
When to See a Doctor

Blood in stool[6] can be alarming. It’s important to know when medical help is needed.
See a doctor if blood in stool lasts more than a day or two. This is especially true if it happens often.
Seek urgent medical attention for these symptoms:
- Large amounts of blood
- Black or tar-like stools
- Dizziness or fainting
- Severe abdominal pain
- Fever above 101°F (38.3°C)
Rectal bleeding[2] can have many causes. Some are minor, but others can be serious.
Don’t ignore blood in your stool, even if it only happens once. It’s best to get checked out.
A doctor can help figure out the cause. They may do tests like:
- Physical exam
- Stool sample test
- Colonoscopy
- Blood tests
Early detection is key for many conditions. Colorectal cancer[1] is one serious possibility that needs quick action.
Remember, only a doctor can give proper medical advice. If you’re worried about blood in your stool, it’s always best to get checked out.
Frequently Asked Questions

Blood in stool can be alarming. Many people have questions about when to seek help and what it means. Let’s address some common concerns.
When should someone be concerned about rectal bleeding?
Rectal bleeding[2] is always a reason to pay attention. Seek medical help if bleeding is heavy, frequent, or comes with pain.
Don’t ignore bleeding that lasts more than a few days. It’s better to be safe and get checked out.
Can certain foods lead to the presence of blood in the bowel movement?
Some foods can cause stool to look red. Beets, red food coloring, and tomato juice are examples.
These don’t cause actual bleeding. But they can be mistaken for blood. If unsure, it’s best to check with a doctor.
How can one differentiate between serious and non-serious causes of hematochezia?
Hematochezia[1] is the medical term for bloody stools. Bright red blood often means the problem is near the end of the digestive tract.
Dark, tarry stools can signal bleeding higher up. This may be more serious. A doctor can help figure out the cause.
What dietary changes are recommended for individuals experiencing bloody stools?
A high-fiber diet can help with some causes of bleeding. Drinking plenty of water is also important.
Avoid alcohol and spicy foods. These can irritate the digestive system. Always talk to a doctor before making big diet changes.
What are the potential implications of blood in the stool for different genders?
Both men and women can have bloody stools. The causes are often similar.
Women might have bleeding related to menstruation. Men might have prostate issues. A doctor can help determine the specific cause.
At what point does the volume of blood in stool indicate a medical emergency?
Large amounts of blood in stool are always an emergency. Seek immediate help[7] if you feel dizzy, weak, or have severe pain.
Even small amounts of blood need checking. Don’t wait if bleeding doesn’t stop after a day or two.
References
- When to worry about blood in your stool (rectal bleeding): Could it be cancer?. https://www.mdanderson.org/cancerwise/when-to-worry-about-blood-in-your-stool.h00-159545268.html Accessed November 27, 2025
- Rectal Bleeding (Blood in Stool): Causes, Colors & Treatments. https://my.clevelandclinic.org/health/symptoms/14612-rectal-bleeding Accessed November 27, 2025
- anus. https://www.health.com/colorectal-cancer-blood-in-stool-explainer-8667647 Accessed November 27, 2025
- Gastrointestinal bleeding - Diagnosis and treatment. https://www.mayoclinic.org/diseases-conditions/gastrointestinal-bleeding/diagnosis-treatment/drc-20372732 Accessed November 27, 2025
- Blogs & News. https://mydoctor.kaiserpermanente.org/mas/news/blood-in-poop-why-it-happens-when-to-be-concerned-1907956 Accessed November 27, 2025
- Rectal bleeding When to see a doctor. https://www.mayoclinic.org/symptoms/rectal-bleeding/basics/when-to-see-doctor/sym-20050740 Accessed November 27, 2025
- Attention Required!. https://www.hopkinsmedicine.org/health/conditions-and-diseases/gastrointestinal-bleeding-or-blood-in-the-stool Accessed November 27, 2025
